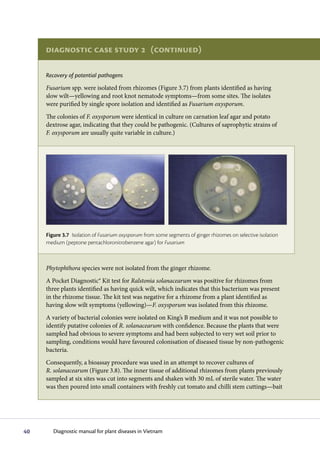
Diagnostic case study 2 (continued)

     Recovery of potential pathogens
     Fusarium spp. were isolated from rhizomes (Figure 3.7) from plants identified as having
     slow wilt—yellowing and root knot nematode symptoms—from some sites. The isolates
     were purified by single spore isolation and identified as Fusarium oxysporum.
     The colonies of F. oxysporum were identical in culture on carnation leaf agar and potato
     dextrose agar, indicating that they could be pathogenic. (Cultures of saprophytic strains of
     F. oxysporum are usually quite variable in culture.)




     Figure 3.7 Isolation of Fusarium oxysporum from some segments of ginger rhizomes on selective isolation
     medium (peptone pentachloronitrobenzene agar) for Fusarium



     Phytophthora species were not isolated from the ginger rhizome.
     A Pocket Diagnostic® Kit test for Ralstonia solanacearum was positive for rhizomes from
     three plants identified as having quick wilt, which indicates that this bacterium was present
     in the rhizome tissue. The kit test was negative for a rhizome from a plant identified as
     having slow wilt symptoms (yellowing)—F. oxysporum was isolated from this rhizome.
     A variety of bacterial colonies were isolated on King’s B medium and it was not possible to
     identify putative colonies of R. solanacearum with confidence. Because the plants that were
     sampled had obvious to severe symptoms and had been subjected to very wet soil prior to
     sampling, conditions would have favoured colonisation of diseased tissue by non-pathogenic
     bacteria.
     Consequently, a bioassay procedure was used in an attempt to recover cultures of
     R. solanacearum (Figure 3.8). The inner tissue of additional rhizomes from plants previously
     sampled at six sites was cut into segments and shaken with 30 mL of sterile water. The water
     was then poured into small containers with freshly cut tomato and chilli stem cuttings—bait




40      Diagnostic manual for plant diseases in Vietnam

The diagnostic process begins with observing symptoms on plants, which can provide clues to the potential pathogens involved. Common symptoms like wilting, yellowing and stunting can have many causes. Specific symptoms like root galls help identify certain pathogens. A single plant may show symptoms from multiple pathogens. Accurate diagnosis may require laboratory analysis. It is important to carefully examine all plant parts and not guess the cause, as an incorrect diagnosis could impact treatment options.

![c
a
b d e
f g h
Figure 4.4 Diseases of the crown, roots and stem: (a) club root of crucifers, (b) wilting of crucifers
(healthy [left] and diseased [right]) caused by club root (Plasmodiophora brassicae), (c) Fusarium wilt
of asters (note the production of sporodochia on the stem), (d) spear point caused by Rhizoctonia sp.,
(e) Phytophthora root rot of chilli, (f) Phytophthora root rot of chilli causing severe wilt, (g) Pythium root
and pod rot of peanuts, (h) perithecia of Gibberella zeae causing stalk rot of maize
50 Diagnostic manual for plant diseases in Vietnam](https://image.slidesharecdn.com/plantdisease-120216150043-phpapp02/85/Plant-disease-19-320.jpg)